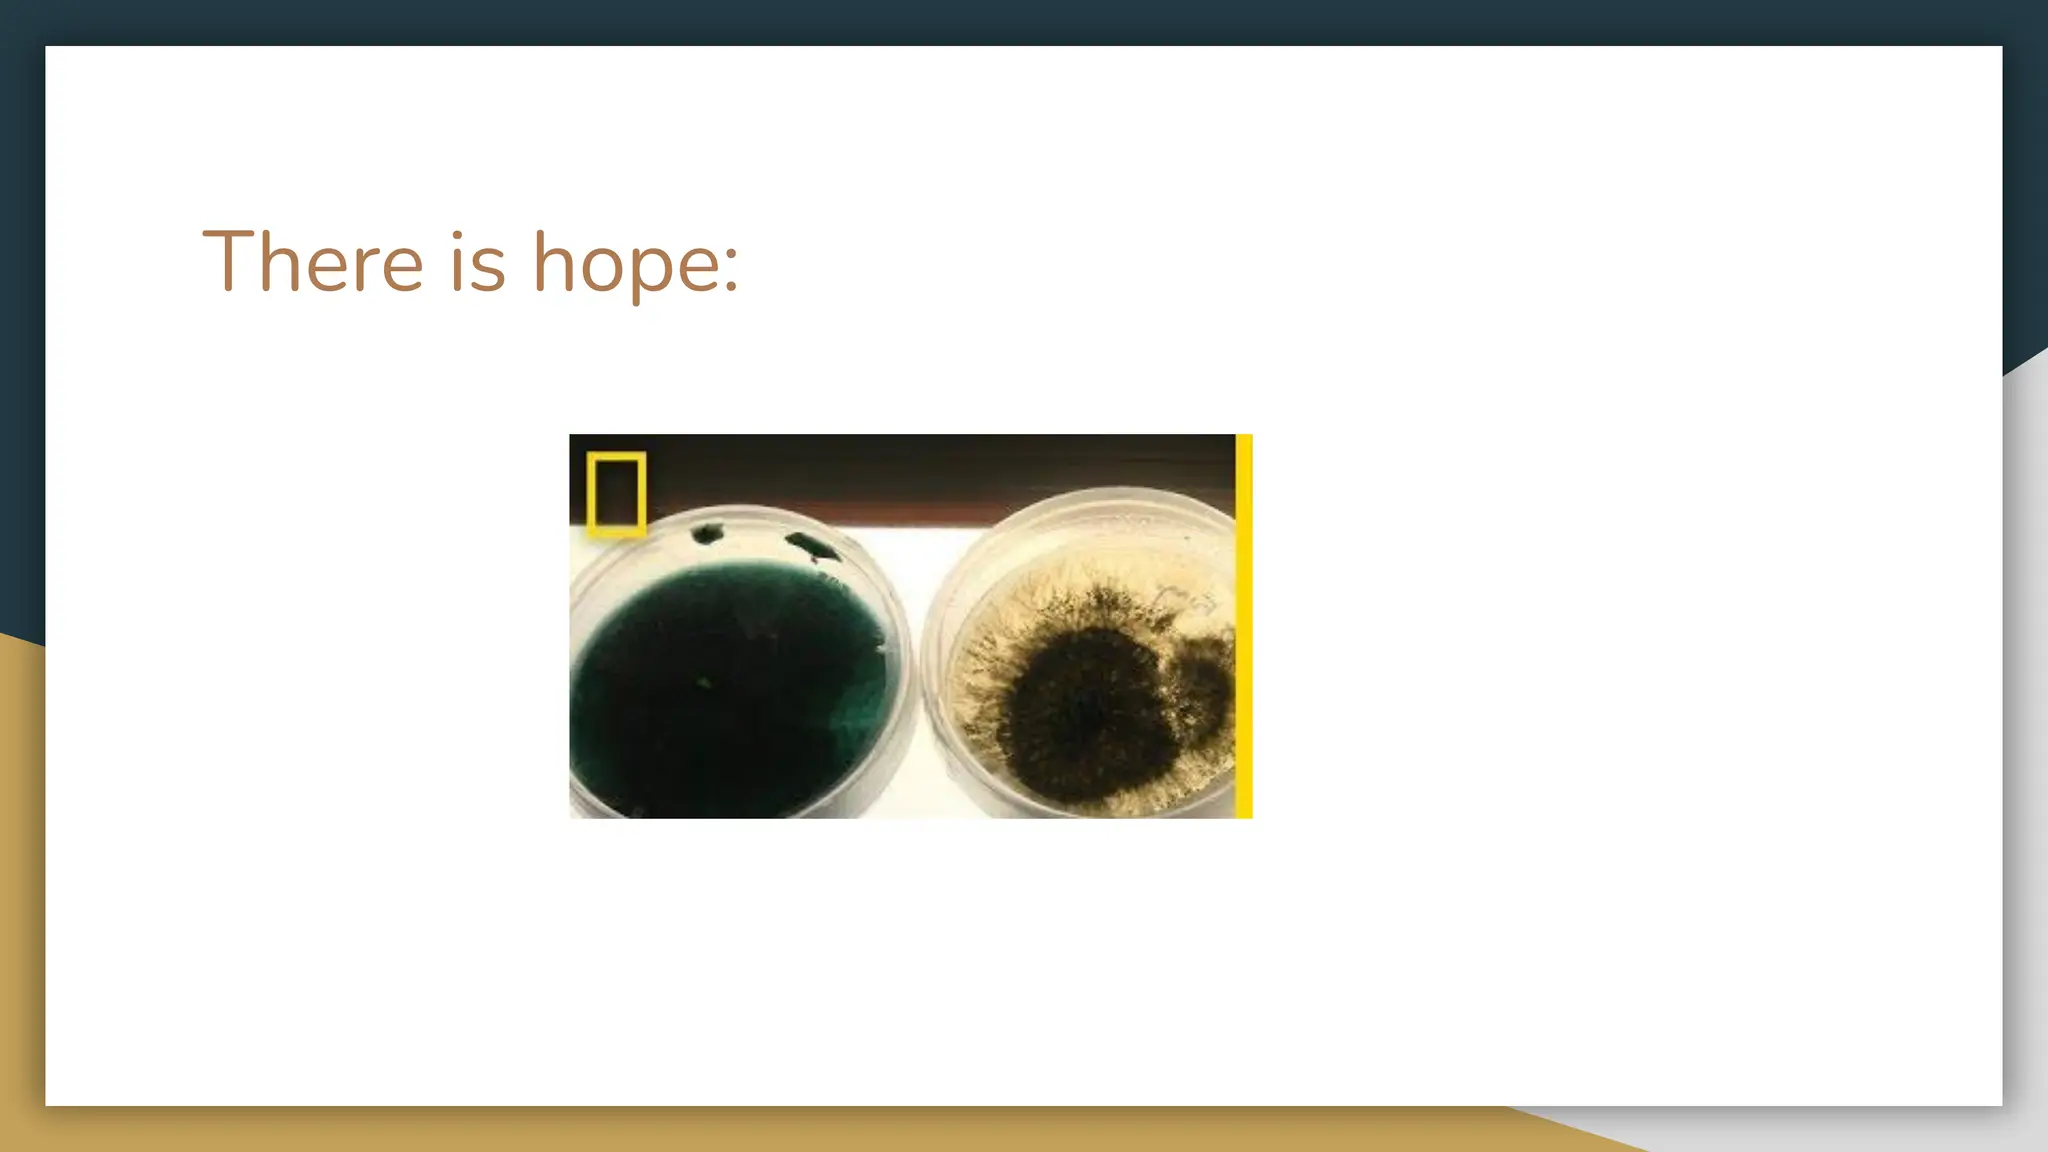
There is hope:

The document discusses the world's dependence on oil resources by explaining how oil is formed over millions of years from the remains of ancient plants and animals, how it is refined into fuel and other products, and some of its widespread uses today such as fueling cars, ships and planes as well as generating electricity. However, it also notes problems with this reliance on oil, such as pollution from oil rigs and refineries, and asks questions about transitioning to more renewable energy sources and electric vehicles.